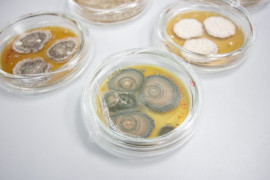

Необычное внеурочное занятие прошло у воспитанников 8 «А» и 8 «Г» классов Ставропольского президентского кадетского училища. Ребята вместе с преподавателем биологии Еленой Владимировной Черкасовой и классными руководителями Еленой Петровной Решетниковой и Юлией Евгеньевной Чумаченко с учебной экскурсией посетили Гематологический музей с лабораторией микроскопических исследований Медико-биологического факультета Северо-Кавказского федерального университета.
Кадеты познакомились с историей изучения крови, донорства, развития микроскопической техники и истории науки о крови, начиная с древнейших времён до современности. Получили много интересной информации о ведущих ученых-гематологов России и Ставропольского края, выдающихся учёных, внесших вклад в развитие гематологии и отмеченным Нобелевскими премиями по медицине и физиологии.
Также восьмиклассники познакомились с коллекцией микроскопических препаратов крови. Аспиранты факультета провели кадетам экскурсии по базовой кафедре микробиологии, анатомии и физиологии, биохимии, молекулярной биологии медицины. На практике кадеты попробовали свои силы в лаборатории микробиологии, анатомии и гистологии и лаборатории микроскопических исследований.
Экскурсия была познавательная и интересная. Особенно кадет заинтересовала экспозиция коллекции микроскопических препаратов крови, клетки которой можно было самостоятельно рассмотреть в лабораторные микроскопы.